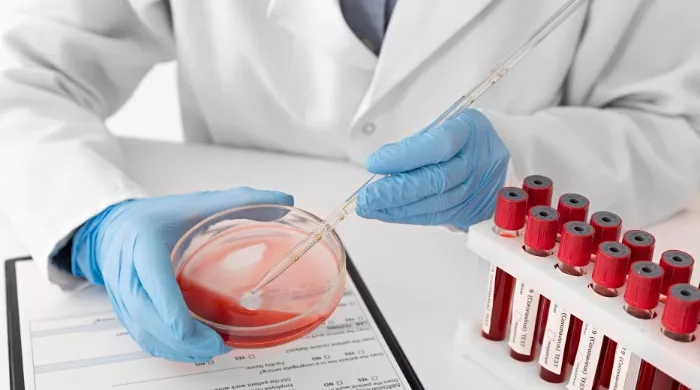
moždanog udara

MOGUĆNOST NASTANKA ŠLOGA
Nedavno istraživanje otkrilo je da krvna grupa osobe može biti povezana sa rizikom od nastanka ranog moždanog udara.
Kakva korelacija postoji između moždanog udara, srčanog udara i krvne grupe? Novo istraživanje otkrilo je vezu koju ne treba potcenjivati.
Moždani udar je cerebrovaskularna bolest, često iznenadnog početka, koja se javlja nakon smanjenja ili prekida dotoka krvi u mozak i posledične smrti moždanih ćelija. Svaki signal koji može predvideti rizik od moždanog udara može biti važan.
S tim u vezi, istraživanje koje je sproveo Medicinski fakultet Univerziteta u Merilendu i objavljeno u časopisu Neurology otkrilo je da krvna grupa osobe može biti povezana sa rizikom od ranog šloga.
Analiza je pokazala da ljudi sa ranim moždanim udarom imaju veću verovatnoću da imaju krvnu grupu A i manje krvnu grupu O, u poređenju sa osobama sa kasnim moždanim udarom i osobama koje nikada nisu imale moždani udar.
Konkretno, oni sa krvnom grupom A imali su 16 odsto veći rizik od ranog moždanog udara od ljudi sa drugim krvnim grupama. Dok su oni sa krvnom grupom O imali 12 odsto manji rizik.
Istraživači još uvek ne znaju razlog za ovu korelaciju, ali se pretpostavlja da je ona povezana sa faktorima zgrušavanja krvi kao što su trombociti i ćelije koje oblažu krvne sudove i drugi cirkulišući proteini, koji igraju ulogu u nastanku krvnih ugrušaka.
Međutim, potrebna su dalja istraživanja kako bi se bolje razjasnili mehanizmi povećanog rizika od moždanog udara.
Izvor: Novilist.hr